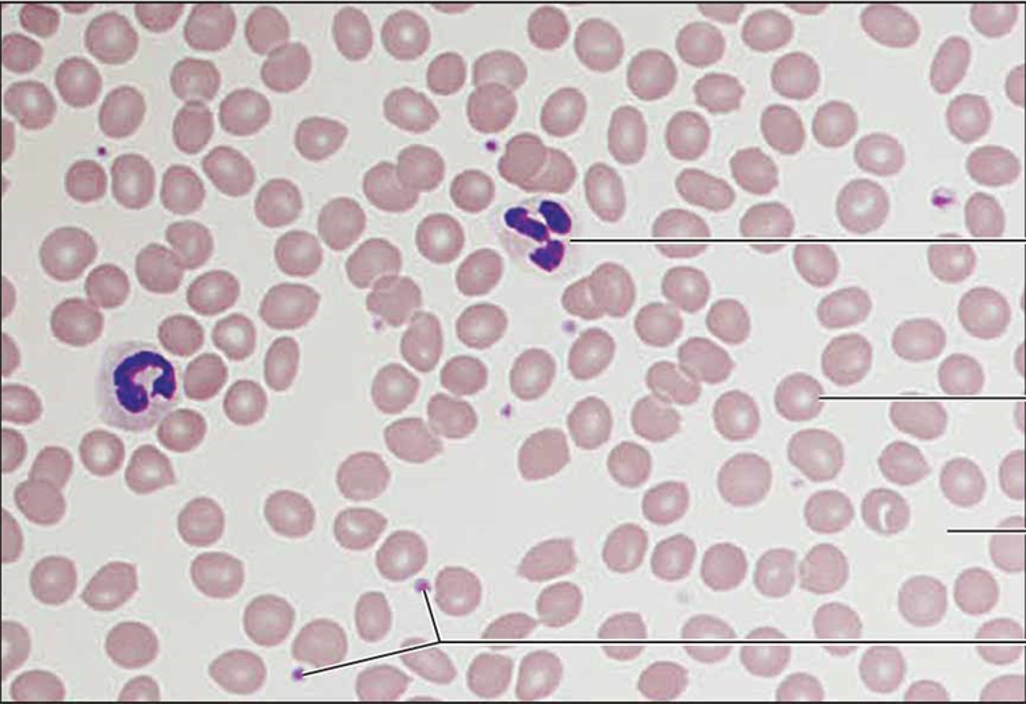
<p>blood connective tissue</p>

1/20
Looks like no tags are added yet.
Name | Mastery | Learn | Test | Matching | Spaced | Call with Kai |
|---|
No analytics yet
Send a link to your students to track their progress

simple squamous epithelium
lining of blood vessels, diffusion

simple cuboidal epithelium
salivary glands, absorption

simple columnar epithelium
stomach, absorption

pseudostratified columnar epithelium
trachea, secretes mucus to trap dust

stratified squamous epithelium
epidermis, resist abrasion

transitional epithelium
urinary bladder, stretching of urinary bladder

skeletal muscle
skeletal muscles, voluntary contraction

smooth muscle
stomach, involuntary contraction

cardiac muscle
heart, contraction of heart

(giant multipolar) neuron
brain, transmit electrical signals from sensory cells to effectors

dense regular connective tissue
tendons, binds bone to bone

reticular connective tissue
lymph nodes, acts as internal skeleton for soft organs

areolar connective tissue
deep in dermis, binds epithelial cells to lower layers

adipose connective tissue
breasts, energy storage

hyaline cartilage connective tissue
ribs, supports conducting passages of respiratory tract

fibrocartilage connective tissue
pubic symphysis, resists compression

elastic cartilage connective tissue
external ear, provides flexible framework

ground bone connective tissue
skeleton, locomotion

spongy bone connective tissue
vertebrae, site of erythropoiesis
blood connective tissue
heart, transports nutrients throughout body

dense irregular connective tissue
dermis, structural support